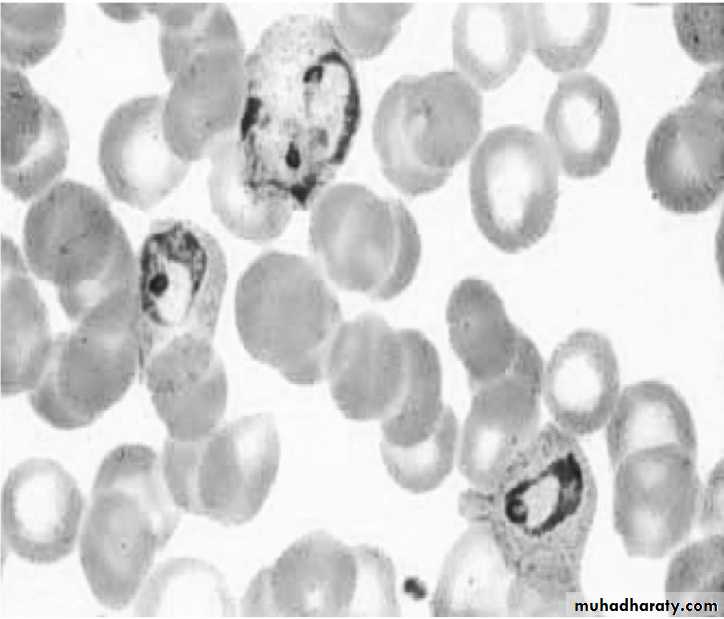
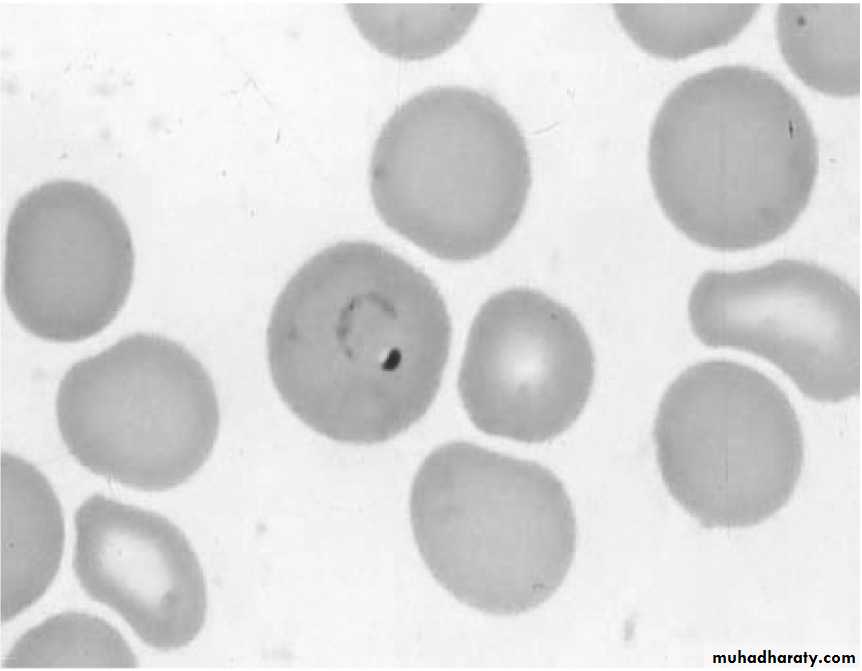
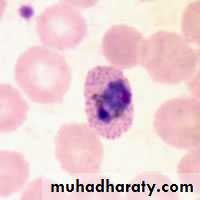
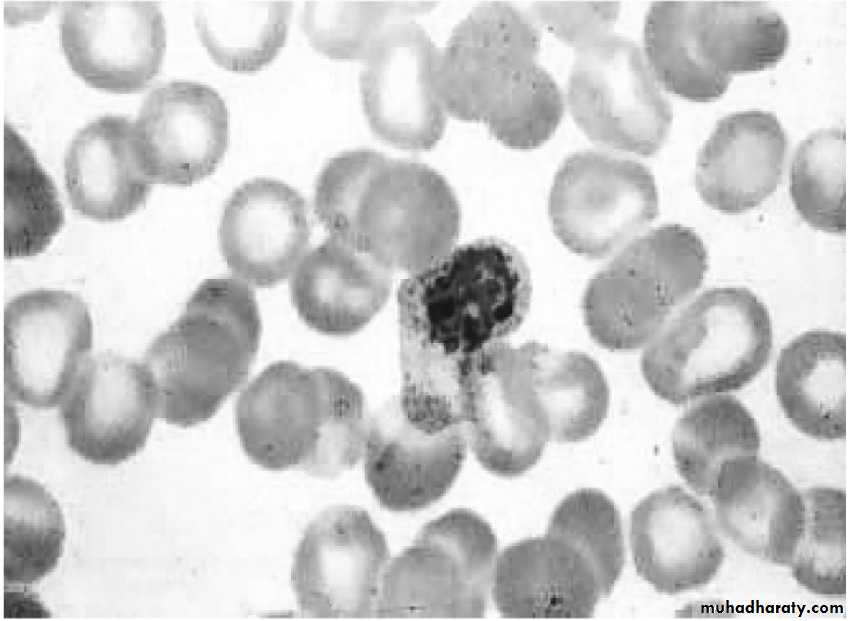
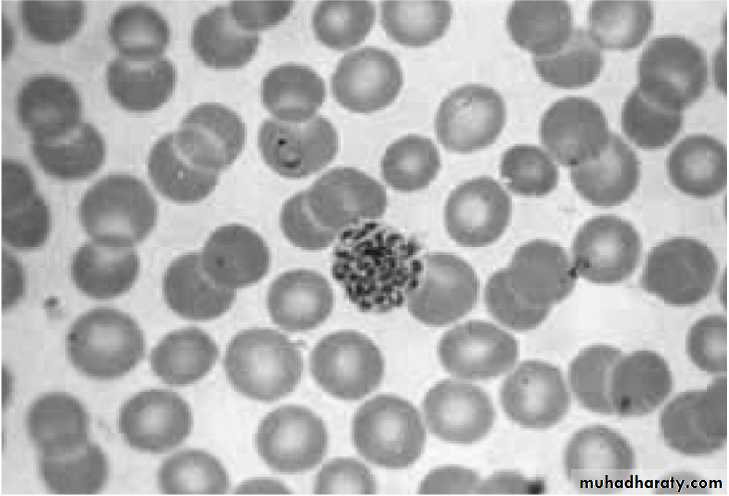

• 4-11-2018
Medical Parasitology3rd class
Blood & Tissue ProtozoaPlasmodium spp.
• Dr. Abdul Rahman Dahham, PhD• Department of Microbiology
• College of Medicine
• Nineveh University
1
MALARIAL PARASITE (plasmodium)
The medically important organisms in this lectures of protozoa consist of the sporozoans Plasmodium and Toxoplasma and the flagellates Trypanosoma and Leishmania.A vector-borne infectious disease caused by protozoan parasites. It is widespread in tropical and subtropical regions. It was once believed that malaria was spread by foul smelling swamp gasses hence the name malaria which literally means “bad air”.
2
A bite from an infected female Anopheles mosquito transmit the disease. Anopheles must be infected through a previous blood meal taken on an infected person to transmit malaria. Malaria is caused primarily by four plasmodia: Plasmodium vivax, Plasmodium ovale, Plasmodium malariae, and Plasmodium falciparum. Plasmodium vivax and P. falciparum are more common causes of malaria than are P. ovale and P. malariae. Plasmodium vivax is most widely distributed and P. falciparum causes the most serious disease.
3
Sporozoa of the genus plasmodium which cause malaria in man are pigment producing amoeboid parasites of vertebrates. They live in red blood cells and hepatocytes.
4
4
Name means “bad air”-
A life-threatening parasitic disease40% of the world’s population is at risk
90% of the deaths due to Malaria occur in Sub-Sahara Africa, mostly among young children.
Around 400-900 million people are affected
At least 2.7 million deaths annually
“Malaria” Facts
5
Disease epidemiology
Class Sporozoa – MalariaMalaria is caused by species of Plasmodium.
The genus Plasmodium contains 172 species, only four species are known to infect humans.
Plasmodium falciparum also known as cerebral malaria) is the most lethal
Plasmodium malariae
Plasmodium ovale
Plasmodium vivax
Plasmodium parasites are highly specific with female Anopheles mosquitoes
6
Each disease has a distinct course
“Tertian Malaria”(P.falciparum, P.ovale and P.vivax)
fever occurs every third day.
“Quartan Malaria”
(P. malariae)fever occurs every fourth day.
· Quartan malaria
· Falciparum malaria
· Blackwater fever
· Tertian malaria
7
All are transmitted by female Anopheles spp. mosquitoes.
“HIV, malaria and TB are among the most important infectious agents in the world.There are no vaccines against them, and all have the same property of establishing chronic infection without an effective immune response.
Geographical distribution - malaria is present worldwide in tropical and subtropical areas.
8
9
Transmission - naturally acquired infections are via the bite of infected female Anopheles mosquitoes. Malaria is also transmitted via blood transfusion, sharing of contaminated needles among IV drug abusers, and congenital transmission also has been documented.
MORPHOLOGY OF PLASMODIUM FALCIPARUM
10In the peripheral smear only two stages the ring form and the gametocytes are always seen.
• The ring form: Early trophozoite- “Ring form”
• containing a reddish chromatin “dot” and blue cytoplasm “ring”.• A ring may contain double chromatin.
• The size of the ring is small and is 2-4 μm.
• Maurier’s dots may be seen in the infected red blood cells. The stain deposits may be confused with the chromatin dot of the ring form
11
(b) Gametocyte form:
Gametocyte, is crescent or banana shaped, cytoplasm in female is more bluish than that of male.
Female gametocyte has compact nucleus while in the male the nucleus is not compact.
Male
Female12
Giemsa stained smear: ring form and gametocytes of Plasmodium falciparum
13
MORPHOLOGY OF PLASMODIUM VIVAX
14In the peripheral smear all the stages of the parasite are seen. These include the trophozoite form, schizont form and the gametocyte form.
• The ring form (trophozoite form):
• Note infected red cell is larger than uninfected red cell.15
Early ring form: P vivax
ii- Growing trophozoite: “Amoeboid form” with “pseudopodia-like” cytoplasmic extension. Note infected red cell is larger than uninfected red cell. Schuffner’s dots appear as fine reddish dots on infected red cell membrane
Growing trophozoite-
“Amoeboid form”Schüffner's dots
(b) Schizont:• Immature schizont: has 2-24 nuclei. Schuffner’s dots appear as fine reddish dots on infected red cell membrane. Infected red cell become irregular in shape and pale in color and enlarged.
(ii) Mature schizont: containing 12-24 merozoites. Schuffner’s dots appear as fine reddish dots on infected red cell membrane.
17
Immature Schizont
Mature Schizont
18
(c) Gametocyte form
round to oval in shape, cytoplasm in female is more bluish than that of male.Female gametocyte has compact nucleus while in the male the nucleus is not compact.
Male
Female19
23
23
Malaria Transmission Cycle
Parasite undergoes sexual reproduction in the mosquitoSome merozoites differentiate into male or female gametocyctes
Erythrocytic Cycle: Merozoites infect red blood cells to form schizonts
Dormant liver stages (hypnozoites) of P. vivax and P. ovale
Exo-erythrocytic (hepatic) Cycle: Sporozoites infect liver cells and develop into schizonts, which release merozoites into the blood
MOSQUITO
HUMAN
Sporozoires injected into human host during blood meal
Parasites mature in mosquito midgut and migrate to salivary glands
25
26
The life cycle of the plasmodium is spent in two hosts’ man and anopheles mosquito.
The mosquito is the definitive host as the sexual development and multiplication of the parasite occurs in it.Man is the intermediate host.
Sporozoite is the infective form of malarial parasite which is passed on to man through the anopheles bite of infected vector.LIFE CYCLE OF MALARIAL PARASITE
27
The main stages of the parasite life cycle in man are:-
(a) Pre-erythrocytic schizogony(b) Erythrocytic schizogony
(c) Gametogony
(d) Exo-erthrocytic schizogony
28
• Pre-erythrocytic schizogony: This phase lasts for 8 days.
Sporozoites are elongated and spindle shaped, enter the liver parenchymal cells and become rounded.
They undergo multiple divisions and develop into schizont. One schizont contains 20,000 – 30,000 merozoites.
The liver cells ruptures and releases the merozoites into blood system.
29(b) Erythocytic schizogony: lasts for 48 hours.
Merozoites penetrate the red blood cells, then they enlarge in size and develop into trophozoites.Trophozoites develop into schizont which further develops into merozoites. There may be 6-24 merozoites in red blood cells.
In the case of Plasmodium falciparum the schizonts aggregate in the capillaries of the brain and other internal organs. So that only ring forms are formed in the peripheral blood.
30
(c) Gametogony phase:
Some merozoites enlarge and get transformed to microgamete and macrogamete.The malarial parasite now becomes infective as the presence of gametocytes that responsible for sexual development in the mosquito.
The mosquito gets these gametocytes after taking a blood meal from a patient of malaria.
31
(d) Exo-erythrocytic schizogony:
Resembles the pre-erythrocytic schizogony.Some sporozoites after entering the liver cells do not undergo multiplication but go into resting phase, which is known as hypnozoite.
These can reactivate up to after 2 years and become schizoints and release merozoites.
This phase is responsible for relapse of malaria32
33
34
Clinical symptoms
Malaria in the blood cell eats the hemoglobin, causing anemia – Dizziness, light-headedness, weakness, arthyalgia (general joint aches).
Body responds with a spikey fever – different species cause different temperatures, cycles and durations.
the disease also alters the cell surface, making it “sticky”, so it sticks to blood vessel walls, causing further anemia and blockage of capillaries in the brain – cerebral malaria.
34
35
P. vivax and P. ovale can hang out in the liver for a long time, longest recorded incubation of P. vivax is 30 years.
They can also go straight from there, and rip up the liver cells – causes hepatitis issues.
Malaria can affect internal organs (spleen, liver, brain, kidneys–Renal failure can manifest as “Blackwater Fever”).
Cerebral issues cause developmental problems in children, especially from repeated infections
35
36
LABORATORY DIAGNOSIS
Microscopy
Demonstration of parasite in blood film:
The definitive diagnosis of malaria is established when the parasite is demonstrated in the blood smear taken from a suspected case of malaria.
The blood smear should preferably be prepared during the febrile phase of malaria, but can be taken at any time that the patient reports for investigation.
36
37
The smears are stained by Romanowsky stains. Lieshman stainn is usually preferred. However staining with Giemsa is also acceptable.
For screening purposes a thick blood smear is prepared. The disadvantage of this smear is that the morphology of the parasite is not visualized properly. For proper morphological identification a thin blood smear which is properly stained is required.
37
38
It must be noted that in P. falciparum infection only the ring form and gametocytes are seen in the peripheral blood smear. While in P. vivax infection all the different stages of the trophozoite and gametocytes are seen.
Thick and thin smears
39Rapid diagnostic test (RDT)
Tests based on immunochromatography (malaria card test). The antigen used for detection of P falciparum infection is HRP II.
39
40
Fluorescent Microscopy
The blood is drawn into the micro-capillary from one end and a fluorescent reagent is drawn in from the other end. This is then centrifuged in a special centrifuge. The centrifugation results in the formation of a buffy coat which contains the parasitized red blood cells. The malarial parasite takes up the
fluorescent dye and the nuclei are seen as pink dots and the body of the parasite is greenish in color. This observed under a special fluorescent microscope.
40
41
Polymerase chain reaction: PCR technique may be employed to diagnose malarial infections in intractable cases. This is a specializeede technique requiring special skills and equipment and is expensive too.
41